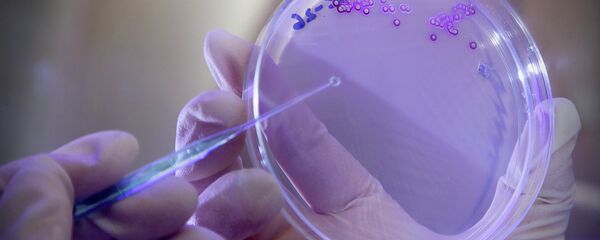
Bactéria - Sputnik Brasil

Cientistas da Escola de Medicina da Universidade de Stanford observaram o movimento ondulatório da morte celular e publicaram as descobertas inovadoras na revista Science.
A equipe detectou sinais que fazem a morte viajar através das células em efeito dominó a uma velocidade de 30 micrômetros por minuto — um micrômetro é equivalente a um milionésimo de metro.
"Este trabalho é outro exemplo de como a natureza faz uso dessas ondas de gatilho – coisas que a maioria dos biólogos nunca ouviu falar", disse o bioquímico James Ferrell.
Os cientistas usaram o ovo de uma rã-de-unhas-africana para realizar o experimento. Depois de remover o citoplasma e colocá-lo em um tubo, eles iniciaram a apoptose e usaram uma proteína verde fluorescente que brilha quando a apoptose ocorre.
O brilho verde se movimentou a uma velocidade constante mostrando que a apoptose estava se espalhando por ondas de gatilho ao invés de difusão química. Os pesquisadores então realizaram o mesmo experimento com um ovo intacto.
As descobertas ampliaram a compreensão dos cientistas sobre a morte celular e podem contribuir com pesquisas relativas ao tratamento do câncer, Alzheimer e outras doenças neurodegenerativas.